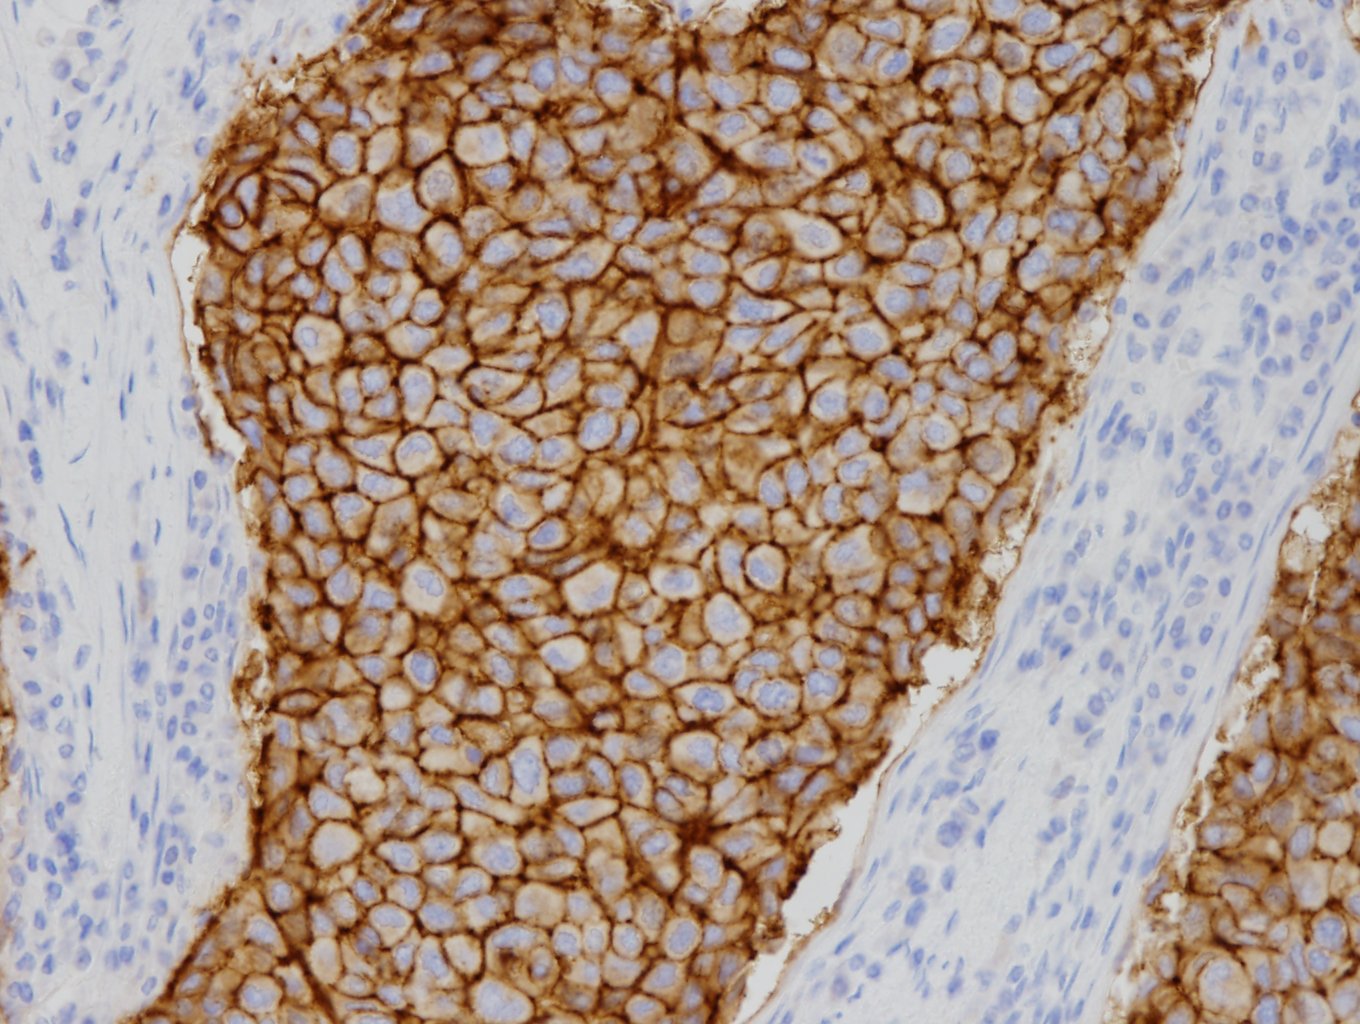
乳癌

IHC・ISH試薬 Molecular Diagnostics Division
保管温度2~8℃
用手法用 ヒストステイナー用 ヒストステイナーAT用
Claudin-4CLDN4
■動物種:ウサギ
■クローン名:EP417
■使用目的:
組織・細胞中のヒトClaudin-4タンパク質の染色
ホルマリン固定パラフィン包埋切片の免疫染色に使用できる。
研究用としてのみ使用すること。
■資料
リーフレット
スクロールで確認できます→
用手法用
ヒストステイナー用
ヒストステイナーAT用
※弊社へお問い合わせください
特異性および抗原分布
ヒトClaudin-4タンパク質と特異的に反応する。Claudin-4は細胞極性を維持する細胞間接着複合体であるタイトジャンクションを構成するClaudinファミリーの1つで、分子量約22kDaの4回膜貫通型タンパク質である(1)~(3)。他のClaudinと相互作用し、孔形成型Claudinが形成するタイトジャンクションの高次構造やイオン透過性を抑制的に調節することで、細胞間のバリア機能を高める(4)(5)。正常では、ほとんどの上皮細胞で発現がみられるが、中皮細胞や肝実質細胞などでは発現がみられない(2)(3)(6)(7)。腫瘍では、肺、乳腺、膵臓、大腸の腺癌および卵巣漿液性癌、腎細胞癌、肺の扁平上皮癌など、ほとんどの癌腫(上皮性腫瘍)で発現がみられるが、上皮様中皮腫では発現がみられないため、癌腫の漿膜転移と上皮様中皮腫との判別において、高い感度と特異度を有する癌腫マーカーであると報告されている(3)(6)。また、胆道癌と肝細胞癌の判別における有用性が示唆されている(2)。
文献
(1) Tabariès S, et al. The role of claudins in cancer metastasis. Oncogene. 2017 Mar 2;36(9):1176-1190.
(2) Lódi C, et al. Claudin-4 differentiates biliary tract cancers from hepatocellular carcinomas. Mod Pathol. 2006 Mar;19(3):460-9.
(3) Ordóñez NG. Value of claudin-4 immunostaining in the diagnosis of mesothelioma. Am J Clin Pathol. 2013 May;139(5):611-9.
(4) Shashikanth N, et al. Tight junction channel regulation by interclaudin interference. Nat Commun. 2022 Jun 30;13(1):3780.
(5) Erramilli SK, et al. Structural and biophysical insights into targeting of claudin-4 by a synthetic antibody fragment. Commun Biol. 2024 Jun 17;7(1):733.
(6) Facchetti F,et al. Claudin 4 identifies a wide spectrum of epithelial neoplasms and represents a very useful marker for carcinoma versus mesothelioma diagnosis in pleural and peritoneal biopsies and effusions. Virchows Arch. 2007 Sep;451(3):669-80.
(7) Husain AN, et al. Guidelines for Pathologic Diagnosis of Mesothelioma: 2023 Update of the Consensus Statement From the International Mesothelioma Interest Group. Arch Pathol Lab Med. 2024 Nov 1;148(11):1251-1271.
食道